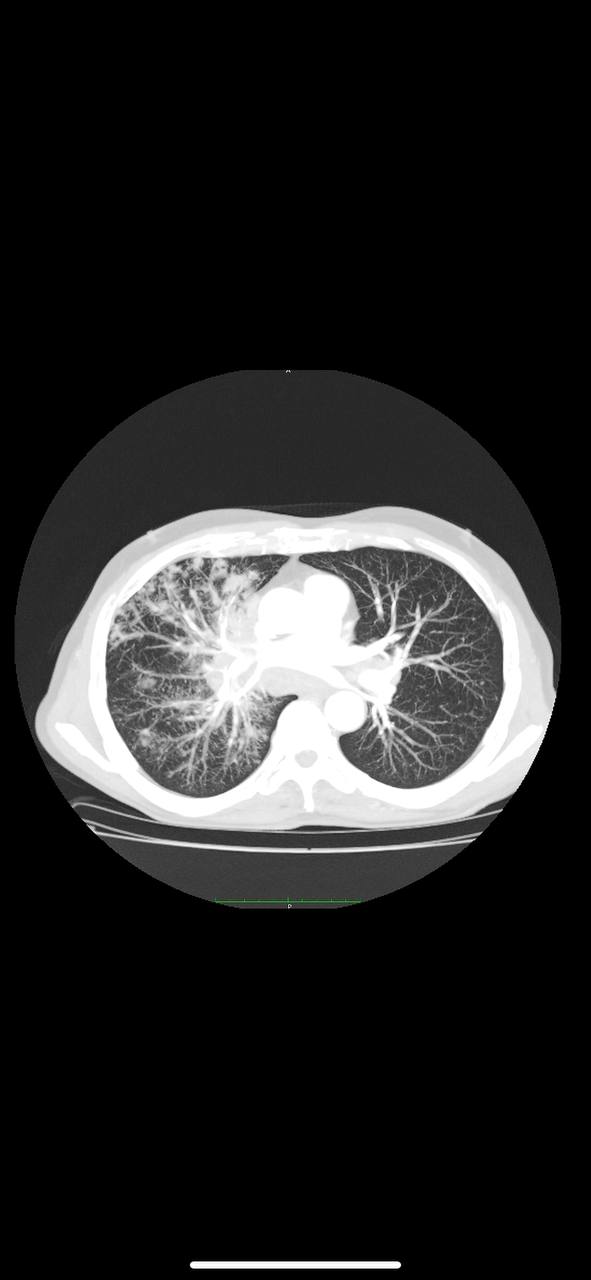

l
Size: a a a
2021 January 25
Можно распечатать и в рамочку
В
похоже на бронхоальвеолярный рак
NL
Из учебника прям
NL
похоже на бронхоальвеолярный рак
Вы одному скану можете сказать?)
Блин.. я б норм скан ещё глянул а не рекон в мип
Блин.. я б норм скан ещё глянул а не рекон в мип
В
к сожалению, это все
NL
По одному скану можно что угодно написать. Хотя итоговая подпись будет все равно того человека который вам это прислал
ЮЦ
петерн дерево в почках ,возможно инфекционка какаято
NL
Юля Цвид
петерн дерево в почках ,возможно инфекционка какаято
+
L
1 Лавкоинов было подарено Юля. Всего у Юля 101 Лавкоинов.
NL
похоже на бронхоальвеолярный рак
-
S
Приветствую вас, Ислам, в одном из первых чатов по рентгенологии в Телеграме.
1.Представьтесь, расскажите нам, кто вы и чем занимаетесь (профессия, образование, регион). Это нужно для того, чтобы все понимали уровень ваших компетенций.
2.Проявляйте уважение к окружающим.
3.В первые 24 часа вам нельзя скидывать снимки во избежание наплыва пациентов/студентов и однодневок.
4.Все дополнительные вопросы к @MMAradiologyofficial
1.Представьтесь, расскажите нам, кто вы и чем занимаетесь (профессия, образование, регион). Это нужно для того, чтобы все понимали уровень ваших компетенций.
2.Проявляйте уважение к окружающим.
3.В первые 24 часа вам нельзя скидывать снимки во избежание наплыва пациентов/студентов и однодневок.
4.Все дополнительные вопросы к @MMAradiologyofficial
И
Ислам , врач рентгенолог
И
🤝
.
Доброго времени✨ есть ли данные за нач-ую Подагру?. 40 лет
R
Здесь только клинически смотреть, артроз 1 х плюснефаланговых есть. Но и только. Ни тофусов, ни всего остального.
2021 January 26
.
RudSycorsky
Здесь только клинически смотреть, артроз 1 х плюснефаланговых есть. Но и только. Ни тофусов, ни всего остального.
Спасибо!) + да, это точно)✨
L
.
Спасибо!) + да, это точно)✨
1 Лавкоинов было подарено RudSycorsky. Всего у RudSycorsky 122 Лавкоинов.